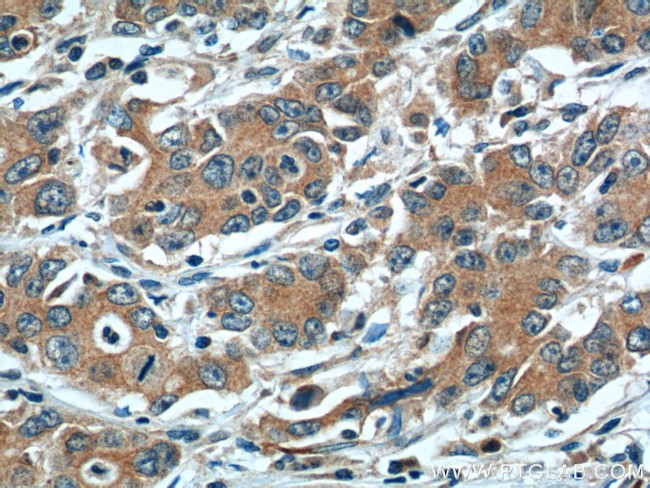
LOX Antibody in Immunohistochemistry (Paraffin) (IHC (P))
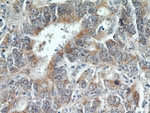
LOX Antibody in Immunohistochemistry (Paraffin) (IHC (P))

Search
Proteintech
LOX Polyclonal Antibody
{{$productOrderCtrl.translations['antibody.pdp.commerceCard.promotion.promotions']}}
{{$productOrderCtrl.translations['antibody.pdp.commerceCard.promotion.viewpromo']}}
{{$productOrderCtrl.translations['antibody.pdp.commerceCard.promotion.promocode']}}: {{promo.promoCode}} {{promo.promoTitle}} {{promo.promoDescription}}. {{$productOrderCtrl.translations['antibody.pdp.commerceCard.promotion.learnmore']}}
产品信息
17958-1-AP
种属反应
已发表种属
宿主/亚型
分类
类型
抗原
偶联物
形式
浓度
规格
纯化类型
保存液
内含物
保存条件
运输条件
产品详细信息
Immunogen sequence: MRFAWTVLL LGPLQLCALV HCAPPAAGQQ QPPREPPAAP GAWRQQIQWE NNGQVFSLLS LGSQYQPQRR RDPGAAVPGA ANASAQQPRT PILLIRDNRT AAARTRTAGS SGVTAGRPRP TARHWFQAGY STSRAREAGA SRAENQTAPG EVPALSNLRP PSRVDGMVGD DPYNPYKYSD DNPYYNYYDT YERPRPGGRY RPGYGTGYFQ YGLPDLVADP YYIQASTYVQ KMSMYNLRCA AEENCLASTA YRADVRDYDH RVLLRFPQRV KNQGTSDFLP SRPRYSWEWH SCHQHYHSMD EFSHYDLLDA NTQRRVAEGH KASFCLEDTS CDYGYHRRFA CTAHTQGLSP GCYDTYGADI DCQWIDITDV KPGNYILKVS VNPSYLVPES DYTNNVVRCD IRYTGHHAYA SGCTISPY (1-417 aa encoded by BC074872)
靶标信息
Lysyl oxidase (LOX), a copper-containing amine oxidase, belongs to a heterogeneous family of enzymes that oxidize primary amine substrates to reactive aldehydes. It plays a vital role in the formation and repair of the extra cellular matrix. As well, LOX is a multifunctional enzyme having diverse biological functions such as developmental regulation, tumor suppression, cell motility and cellular senescence. The secreted form of LOX is responsible for the invasive properties of hypoxic human cancer cells. Thus, it is essential for hypoxia-induced metastasis and is a good therapeutic target for preventing and treating metastases.
仅用于科研。不用于诊断过程。未经明确授权不得转售。
生物信息学
蛋白别名: expressed during ripening fruit; loxC; loxc homologue; Lysyl oxidase; MGC105112; Protein-lysine 6-oxidase; Ras excision protein; ras recision; TomloxC; unnamed protein product
基因别名: AAT10; AI893619; LOX; Rrg; TSC-160
UniProt ID: (Human) P28300, (Mouse) P28301
Entrez Gene ID: (Human) 4015, (Mouse) 16948